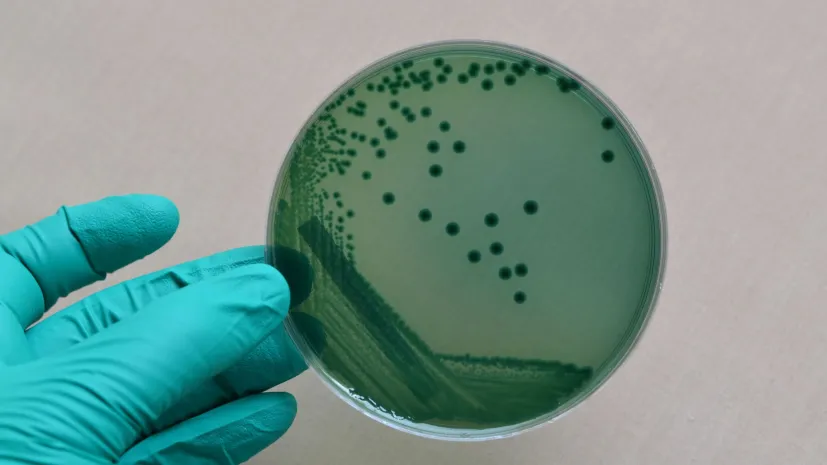

Wrocław/ Lekarze wyleczyli dziecko, które chorowało na błonicę
Lekarze wyleczyli sześcioletnie dziecko, które było chore na błonicę. W środę opuściło szpital - poinformowała w czwartek rzeczniczka Wojewódzkiego Szpitala Specjalistycznego we Wrocławiu Janina Kulińska. Dorosły chory opuścił szpital w zeszłym tygodniu.
-

Błonica - choroba groźna także dla dorosłych
Błonicę w Europie praktycznie wyeliminowało wprowadzenie obowiązkowych szczepień. Choć choroba atakuje głównie dzieci, zachorować mogą na nią także zaszczepione osoby dorosłe, jeśli szczepienia nie są powtarzane. Co więcej, po 40. roku życia choroba staje się równie groźna, co we wczesnym dzieciństwie.
-

Ekspert: zainteresowanie błonicą w ostatnim tygodniu większe niż wyborami
Zainteresowanie błonicą w internecie w minionym tygodniu było większe niż wyborami prezydenckimi – powiedział w środę PAP przewodniczący Europejskiego Kolektywu Analitycznego Res Futura Michał Fedorowicz. Dodał, że w dyskusji w sieci na temat tej choroby dominują komentarze antyszczepionkowców.
-

Epidemiolodzy: pęka nasz klosz bezpieczeństwa epidemiologicznego
Z powodu stylu życia i braku szczepień przypominających wśród dorosłych pęka klosz bezpieczeństwa epidemiologicznego – powiedział naczelny epidemiolog Uniwersyteckiego Szpitala Klinicznego we Wrocławiu prof. Jarosław Drobnik. Zalecił, by ponawiać szczepienia.
-

Błonica - choroba nieco w Polsce zapomniana
Błonica to przykład choroby zakaźnej, którą w Europie praktycznie wyeliminowało wprowadzenie obowiązkowych szczepień. Obecnie w europejskich krajach zgony z powodu błonicy zdarzają się raz na kilkadziesiąt lat, zwykle u niezaszczepionych dzieci. Gorzej wygląda sytuacja w Afryce czy Azji.
-

Uodporniona na leki błonica może znów stać się globalnym zagrożeniem
Powodująca błonicę (dyfteryt) bakteria staje się odporna na antybiotyki, a pandemia COVID-19 zakłóciła przebieg szczepień, które skutecznie chronią przed zachorowaniem – informuje pismo “Nature Communications”.
Najpopularniejsze
-

Piorun, który wysłał błysk gamma ku ziemi
-
Archeolodzy ustalili, kiedy mogła umrzeć inkaska „Dziewczyna z Llullaillaco”
-
Ekspertki: najgroźniejsze kłamstwa medyczne ubierają się w kostium prawdy
-
Zdobywczyni grantu ERC: system prawny wymaga rekonstrukcji pod kątem kobiet i mniejszości
-
Eksperci: przewlekła obturacyjna choroba płuc to trzecia przyczyna zgonów w Polsce















